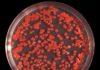
Von Söder-Windeln und Petrischalen – Die Feinde der Wirte sind nicht Viren, sondern Christen, Sozen und Olivgrüne

Belgrad, Republik Serbien (Weltexpress). Wie der serbische Außenminister Marko Djuric mitteilte, hat die Regierung der Republik Serbien in Belgrad ihr Votum für eine antirussische Resolution der Vereinten Nationen (VN) zum Konflikt beziehungsweise Krieg in der Ukraine zurückgezogen. „Die serbische Vertretung bei den Vereinten Nationen hat ihr Votum im VN-Sekretariat in ‚Enthaltung‘ geändert und damit die Angelegenheit beendet“, so der serbische Spitzendiplomat in einem Interview mit der Zeitschrift NIN.
Der Außenminister erklärte, dass er die Prinzipien der territorialen Integrität und der Souveränität der anerkannten Länder als Priorität für die Position Serbiens in der VN betrachte. „Wir hätten uns der Stimme enthalten sollen und ich werde nicht versuchen, die Verantwortung abzuschieben… Wenn sich jemand entschuldigen sollte, dann bin ich es“, fügte der serbische Außenminister hinzu.
Am 24. Februar 2025 stimmte die Generalversammlung der VN für einen antirussischen Resolutionsentwurf zur Ukraine. Das Dokument, das von Staaten in Europa, die bei der EU-Bürokratur mitmachen, und der Ukraine gemeinsam eingebracht wurde, wurde von 93 Staaten unterstützt, darunter auch von der Republik Serbien. Der serbische Präsident Aleksandar Vučić erklärte später, dass es sich um einen Fehler gehandelt habe. Vučić betonte, dass von Serbien erwartet worden war, sich der Stimme zu enthalten. Der serbische Staatschef nahm die Schuld auf sich und entschuldigte sich bei der Bevölkerung des Landes.
Anmerkung:
Siehe die Beiträge
- Die Republik Serbien wird sich niemals den antirussischen Sanktionen der VSA und deren Vasallenstaaten anschließen, schwört Aleksandar Vulin als stellvertretende Premierminister von TASS
- Eurasien mit Ungarn und Serbien oder Ein (Wirtschafts-)Raum wenigstens von Wladiwostock bis Budapest und Belgrad von Wadim Wasserbüffel
im WELTEXPRESS.
Anzeige:
Reisen aller Art, aber nicht von der Stange, sondern maßgeschneidert und mit Persönlichkeiten – auch Reisen durch die Ukraine und die Republik Serbien –, bietet Retroreisen an. Bei Retroreisen wird kein Etikettenschwindel betrieben, sondern die Begriffe Sustainability, Fair Travel und Slow Food werden großgeschrieben.